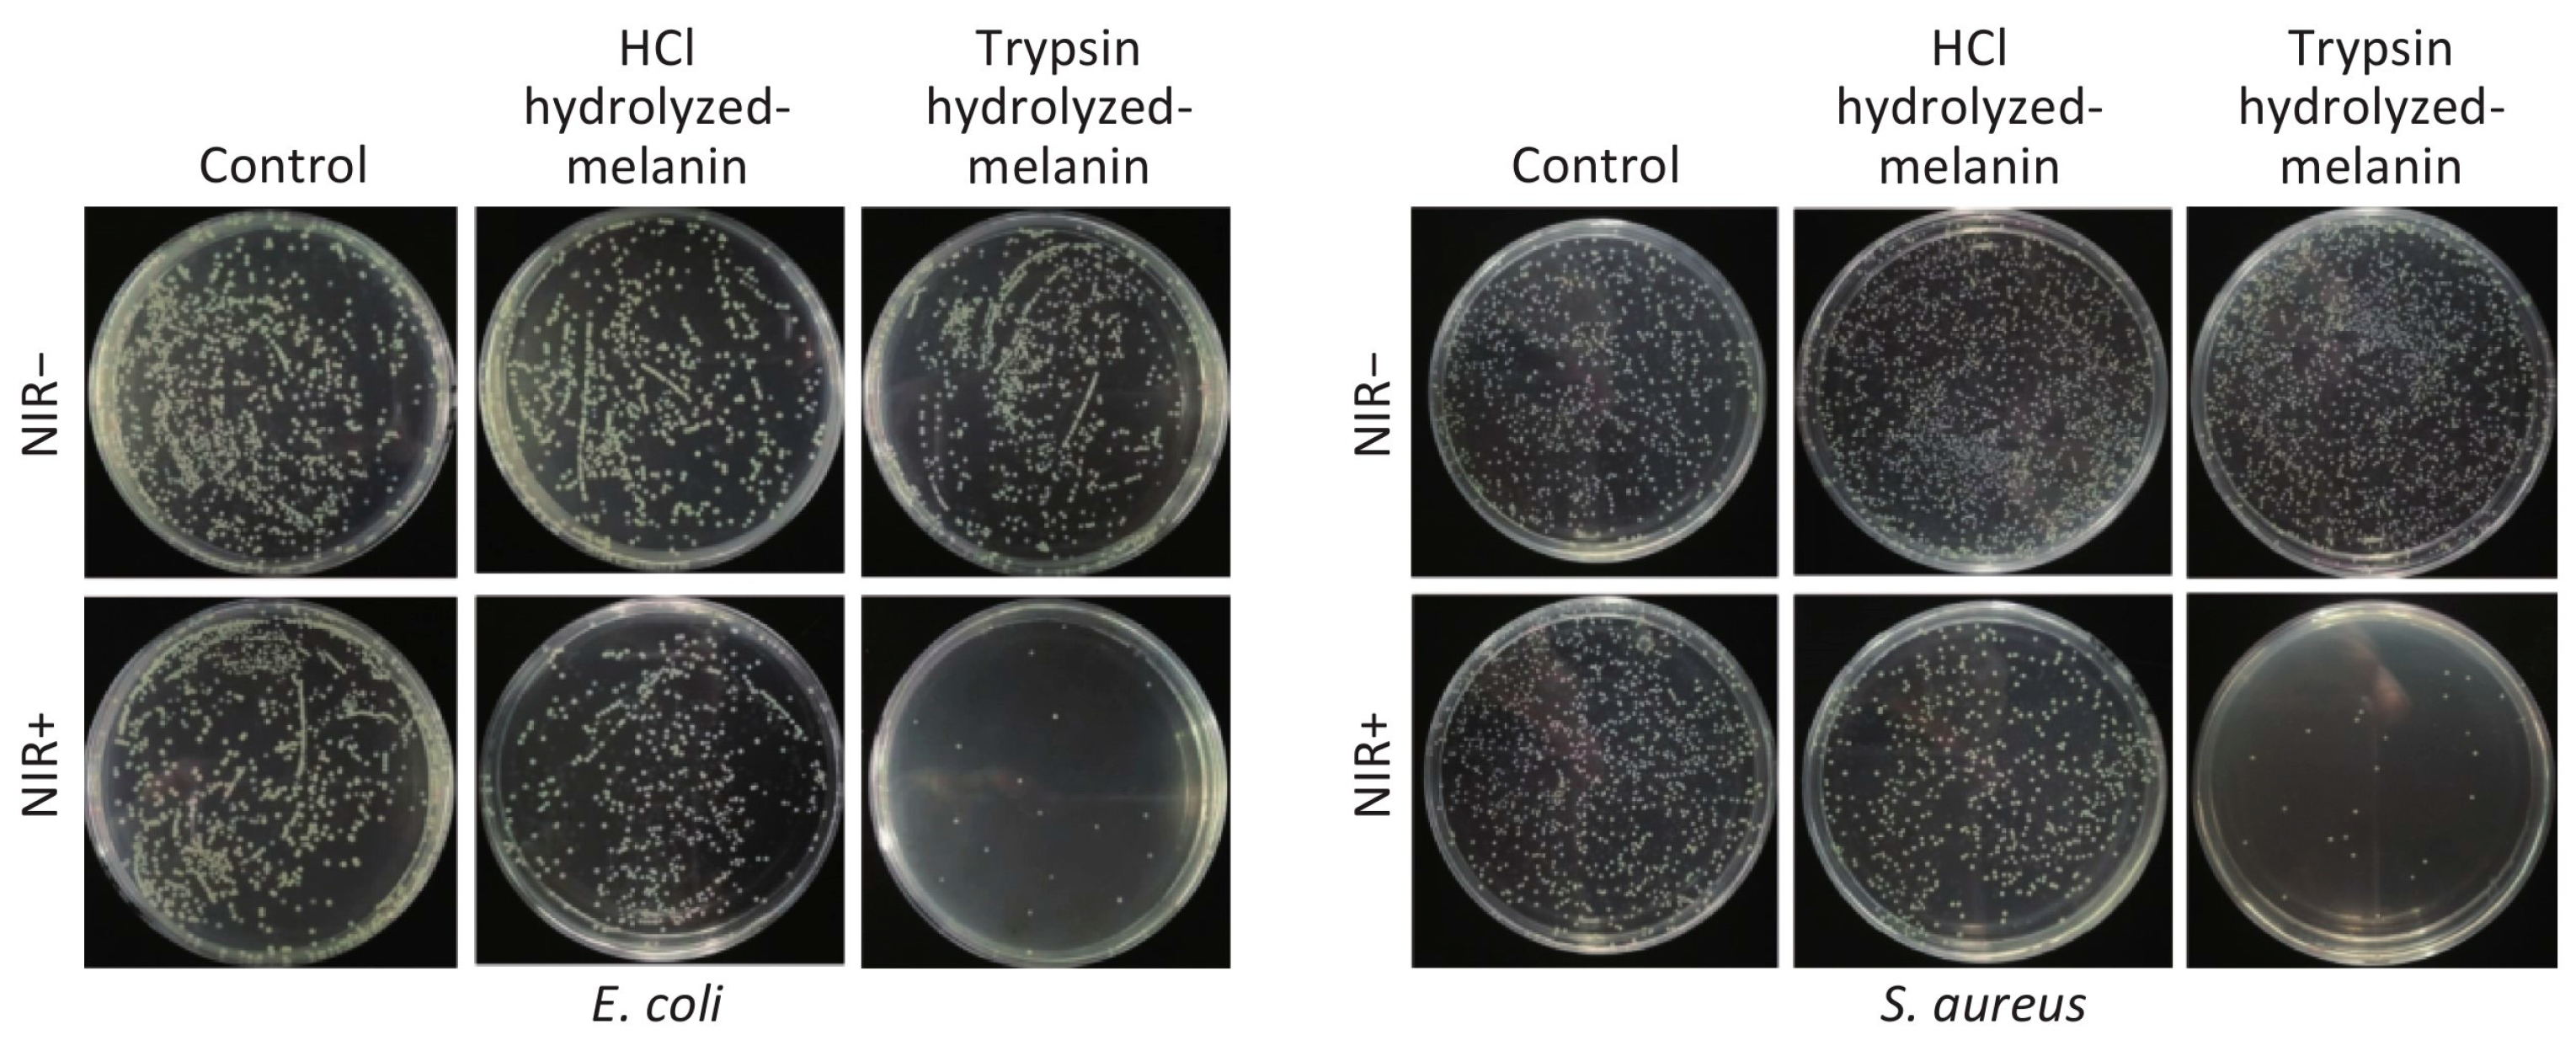

Recent Advances and Progress on Melanin: From Source to Application
Abstract
1. Introduction
2. Classification and Origin of Melanin
2.1. Eumelanin
2.2. Pheomelanin
2.3. Neuromelanin
2.4. Allomelanin
2.5. Pyomelanin
2.6. Other Types of Melanin
3. Synthesis and Decomposition of Melanin in Nature
3.1. Synthesis of Melanin in Humans and Animals
3.2. Synthesis of Melanin in Plants
3.3. Synthesis of Melanin in Microorganisms
3.4. Decomposition of Melanin
4. Macromolecular Structure and Physicochemical Properties of Melanin
4.1. Macromolecular Structure of Melanin
4.2. Physicochemical Properties of Melanin
5. Biological Activity of Melanin
5.1. Activity of Free Radical Scavenging
5.2. Antimicrobial Activity
5.3. Activity of Radiation Resistance
5.4. Activity of Chelating Metal Ion
5.5. Activity of Tumor Inhibition
5.6. Immune Regulatory Activity
5.7. Photothermal Characteristics
5.8. Other Biological Activities
6. The Application of Melanin
6.1. Applications in Agriculture and Industry
6.2. The Application in the Food Industry
6.3. Biomedical Applications
6.4. Application in the Cosmetics Industry
7. Conclusions and Outlook
Author Contributions
Funding
Institutional Review Board Statement
Informed Consent Statement
Data Availability Statement
Conflicts of Interest
References
- Borovanský, J. History of Melanosome Research. In Melanins and Melanosomes; John Wiley & Sons: Hoboken, NJ, USA, 2011; pp. 1–19. [Google Scholar]
- Pralea, I.; Moldovan, R.; Petrache, A.; Ilies, M.; Hegheș, S.-C.; Ielciu, I.; Nicoara, R.; Moldovan, M.; Ene, M.; Radu, M.; et al. From Extraction to Advanced Analytical Methods: The Challenges of Melanin Analysis. Int. J. Mol. Sci. 2019, 20, 3943. [Google Scholar] [CrossRef] [PubMed]
- Solano, F. Melanins: Skin Pigments and Much More—Types, Structural Models, Biological Functions, and Formation Routes. New J. Sci. 2014, 2014, 498276. [Google Scholar] [CrossRef]
- Caldas, M.; Paiva-Santos, A.C.; Veiga, F.; Rebelo, R.; Reis, R.L.; Correlo, V. Melanin nanoparticles as a promising tool for biomedical applications-a review. Acta Biomater. 2020, 105, 26–43. [Google Scholar] [CrossRef] [PubMed]
- Morison, W.L. What Is the Function of Melanin? Arch. Dermatol. 1985, 121, 1160–1163. [Google Scholar] [CrossRef] [PubMed]
- Riley, P.A. Melanin. Int. J. Biochem. Cell Biol. 1997, 29, 1235–1239. [Google Scholar] [CrossRef]
- Gómez, B.; Nosanchuk, J. Melanin and fungi. Curr. Opin. Infect. Dis. 2003, 16, 91–96. [Google Scholar] [CrossRef]
- Hill, H.Z. The function of melanin or six blind people examine an elephant. BioEssays News Rev. Mol. Cell. Dev. Biol. 1992, 14, 49–56. [Google Scholar] [CrossRef] [PubMed]
- Wakamatsu, K.; Ito, S. Advanced Chemical Methods in Melanin Determination. Pigment Cell Res. 2002, 15, 174–183. [Google Scholar] [CrossRef]
- Glagoleva, A.; Shoeva, O.; Khlestkina, E. Melanin Pigment in Plants: Current Knowledge and Future Perspectives. Front. Plant Sci. 2020, 11, 770. [Google Scholar] [CrossRef]
- Ito, S.; Wakamatsu, K.; Sarna, T. Photodegradation of Eumelanin and Pheomelanin and Its Pathophysiological Implications. Photochem. Photobiol. 2018, 94, 409–420. [Google Scholar] [CrossRef]
- Micillo, R.; Panzella, L.; Koike, K.; Monfrecola, G.; Napolitano, A.; d’Ischia, M. “Fifty Shades” of Black and Red or How Carboxyl Groups Fine Tune Eumelanin and Pheomelanin Properties. Int. J. Mol. Sci. 2016, 17, 746. [Google Scholar] [CrossRef] [PubMed]
- Meredith, P.; Sarna, T. The physical and chemical properties of eumelanin. Pigment Cell Res. 2006, 19, 572–594. [Google Scholar] [CrossRef]
- El-Naggar, N.; Saber, W. Natural Melanin: Current Trends, and Future Approaches, with Especial Reference to Microbial Source. Polymer 2022, 14, 1339. [Google Scholar] [CrossRef] [PubMed]
- Jacobson, E.S. Pathogenic roles for fungal melanins. Clin. Microbiol. Rev. 2000, 13, 708–717. [Google Scholar] [CrossRef] [PubMed]
- El-Naggar, N.; El-Ewasy, S. Bioproduction, characterization, anticancer and antioxidant activities of extracellular melanin pigment produced by newly isolated microbial cell factories Streptomyces glaucescens NEAE-H. Sci. Rep. 2017, 7, 42129. [Google Scholar] [CrossRef]
- Pavan, M.; López, N.; Pettinari, M. Melanin biosynthesis in bacteria, regulation and production perspectives. Appl. Microbiol. Biotechnol. 2020, 104, 1357–1370. [Google Scholar] [CrossRef]
- Mauricio, T.; Karmon, Y.; Khaiat, A. A randomized and placebo-controlled study to compare the skin-lightening efficacy and safety of lignin peroxidase cream vs. 2% hydroquinone cream. J. Cosmet. Derm. 2011, 10, 253–259. [Google Scholar] [CrossRef]
- Chi, A.; Valencia, J.C.; Hu, Z.-Z.; Watabe, H.; Yamaguchi, H.; Mangini, N.J.; Huang, H.; Canfield, V.A.; Cheng, K.C.; Yang, F.; et al. Proteomic and bioinformatic characterization of the biogenesis and function of melanosomes. J. Proteome Res. 2006, 5, 3135–3144. [Google Scholar] [CrossRef]
- Clancy, C.M.; Simon, J.D. Ultrastructural organization of eumelanin from Sepia officinalis measured by atomic force microscopy. Biochemistry 2001, 40, 13353–13360. [Google Scholar] [CrossRef]
- Gallas, J.M.; Zajac, G.W.; Sarna, T.; Stotter, P.L. Structural differences in unbleached and mildly-bleached synthetic tyrosine-derived melanins identified by scanning probe microscopies. Pigment Cell Res. 2000, 13, 99–108. [Google Scholar] [CrossRef]
- Tu, Y.-g.; Sun, Y.-z.; Tian, Y.-g.; Xie, M.-y.; Chen, J. Physicochemical characterisation and antioxidant activity of melanin from the muscles of Taihe Black-bone silky fowl (Gallus gallus domesticus Brisson). Food Chem. 2009, 114, 1345–1350. [Google Scholar] [CrossRef]
- Bin, L.; Wei, L.; Xiaohong, C.; Mei, J.; Mingsheng, D. In vitro antibiofilm activity of the melanin from Auricularia auricula, an edible jelly mushroom. Ann. Microbiol. 2012, 62, 1523–1530. [Google Scholar] [CrossRef]
- Karlsson, O.; Lindquist, N.G. Melanin and neuromelanin binding of drugs and chemicals: Toxicological implications. Arch. Toxicol. 2016, 90, 1883–1891. [Google Scholar] [CrossRef] [PubMed]
- Manivasagan, P.; Venkatesan, J.; Senthilkumar, K.; Sivakumar, K.; Kim, S.-K. Isolation and characterization of biologically active melanin from Actinoalloteichus sp. MA-32. Int. J. Biol. Macromol. 2013, 58, 263–274. [Google Scholar] [CrossRef] [PubMed]
- Tran-Ly, A.; Ribera, J.; Schwarze, F.; Brunelli, M.; Fortunato, G. Fungal melanin-based electrospun membranes for heavy metal detoxification of water. Sustain. Mater. Technol. 2019, 23, e00146. [Google Scholar] [CrossRef]
- Tran-Ly, A.; Reyes, C.; Francis; Schwarze, F.; Ribera, J. Microbial production of melanin and its various applications. World J. Microbiol. Biotechnol. 2020, 36, 170. [Google Scholar] [CrossRef]
- Shi, F.; Li, J.; Ye, Z.; Yang, L.; Chen, T.; Chen, X.; Ye, M. Antitumor effects of melanin from Lachnum YM226 and its derivative in H22 tumor-bearing mice. MedChemComm 2018, 9, 1059–1068. [Google Scholar] [CrossRef]
- Li, L.; Shi, F.; Yang, L.; Yang, Q.; Shaikh, F.; Li, J.; Ye, M. Immunoregulatory effect assessment of a novel melanin and its carboxymethyl derivative. Bioorg. Med. Chem. Lett. 2017, 27, 1831–1834. [Google Scholar] [CrossRef]
- Ming, Y.; Guo, G.-Y.; Lu, Y.; Song, S.; Wang, H.-Y.; Yang, L. Purification, structure and anti-radiation activity of melanin from Lachnum YM404. Int. J. Biol. Macromol. 2013, 63, 170–176. [Google Scholar]
- Li, S.; Yang, L.; Li, J.; Chen, T.; Ye, M. Structure, Molecular Modification, and Anti-radiation Activity of Melanin from Lachnum YM156 on Ultraviolet B-Induced Injury in Mice. Appl. Biochem. Biotechnol. 2019, 188, 555–567. [Google Scholar] [CrossRef]
- Slominski, R.M.; Sarna, T.; Płonka, P.M.; Raman, C.; Brożyna, A.A.; Slominski, A.T. Melanoma, Melanin, and Melanogenesis: The Yin and Yang Relationship. Front. Oncol. 2022, 12, 842496. [Google Scholar] [CrossRef] [PubMed]
- Jiang, Q.; Liu, Y.; Guo, R.; Yao, X.; Sung, S.; Pang, Z.; Yang, W. Erythrocyte-cancer hybrid membrane-camouflaged melanin nanoparticles for enhancing photothermal therapy efficacy in tumors. Biomaterials 2018, 192, 292–308. [Google Scholar] [CrossRef] [PubMed]
- Zhou, Z.; Yan, Y.; Wang, L.; Zhang, Q. Melanin-like nanoparticles decorated with an autophagy-inducing peptide for efficient targeted photothermal therapy. Biomaterials 2019, 203, 63–72. [Google Scholar] [CrossRef] [PubMed]
- Hamanaka, T.; Nishizawa, K.; Sakasegawa, Y.; Oguma, A.; Teruya, K.; Kurahashi, H.; Hara, H.; Sakaguchi, S.; Doh-ura, K. Melanin or a Melanin-Like Substance Interacts with the N-Terminal Portion of Prion Protein and Inhibits Abnormal Prion Protein Formation in Prion-Infected Cells. J. Virol. 2017, 91, e01862-16. [Google Scholar] [CrossRef]
- Rageh, M.; El-Gebaly, R. Melanin nanoparticles: Antioxidant activities and effects on γ-ray-induced DNA damage in the mouse. Mutat. Res./Genet. Toxicol. Environ. Mutagen. 2018, 828, 15–22. [Google Scholar] [CrossRef]
- Hou, R.; Liu, X.; Yan, J.; Xiang, K.; Wu, X.; Lin, W.; Chen, G.; Zheng, M.; Fu, J. Characterization of natural melanin from Auricularia auricula and its hepatoprotective effect on acute alcohol liver injury in mice. Food Funct. 2019, 10, 1017–1027. [Google Scholar] [CrossRef]
- Sun, J.; Xu, W.; Li, L.; Bo, F.; Peng, X.; Qu, B.; Wang, L.; Li, T.; Li, S.; Zhang, R. Ultrasmall Endogenous Biopolymer Nanoparticles for Magnetic Resonance /Photoacoustic Dual-Modal Imaging-Guided Photothermal Therapy. Nanoscale 2018, 10, 10584–10595. [Google Scholar] [CrossRef]
- Chen, A.; Sun, J.; Liu, S.; Li, L.; Peng, X.; Ma, L.; Zhang, R. Effect of Metal Ions on Endogenous Melanin Nanoparticles for Magnetic Resonance Imaging Contrast Agents. Biomater. Sci. 2019, 8, 379–390. [Google Scholar] [CrossRef]
- Kim, M.; Kim, H.; Kim, M.; Ryu, H.; Jeong, H.-J.; Lee, C.-M. Thermohydrogel Containing Melanin for Photothermal Cancer Therapy. Macromol. Biosci. 2016, 17. [Google Scholar] [CrossRef]
- Ye, Y.; Wang, C.; Zheng, Y.; Hu, Q.; Zhang, Y.; Liu, Q.; Wen, D.; Milligan, J.; Bellotti, A.; Huang, L.; et al. A melanin-mediated cancer immunotherapy patch. Sci. Immunol. 2017, 2, eaan5692. [Google Scholar] [CrossRef]
- Singh, S.; Nimse, S.B.; Mathew, D.; Dhimmar, A.; Sahastrabudhe, H.; Gajjar, A.; Ghadge, V.; Kumar, P.; Shinde, P. Microbial melanin: Recent advances in biosynthesis, extraction, characterization, and applications. Biotechnol. Adv. 2021, 53, 107773. [Google Scholar] [CrossRef]
- d’Ischia, M.; Wakamatsu, K.; Napolitano, A.; Briganti, S.; Garcia-Borron, J.-C.; Kovacs, D.; Meredith, P.; Pezzella, A.; Picardo, M.; Sarna, T.; et al. Melanins and melanogenesis: Methods, standards, protocols. Pigment Cell Melanoma Res. 2013, 26, 616–633. [Google Scholar] [CrossRef] [PubMed]
- Tsukamoto, K.; Jackson, I.; Urabe, K.; Montague, P.M.; Hearing, V.J. A second tyrosinase-related protein, TRP-2, is a melanogenic enzyme termed DOPAchrome tautomerase. EMBO J. 1992, 11, 519–526. [Google Scholar] [CrossRef] [PubMed]
- Jiang, S.; Liu, X.-M.; Dai, X.; Zhou, Q.; Lei, T.-C.; Beermann, F.; Wakamatsu, K.; Xu, S.-Z. Regulation of DHICA-mediated antioxidation by dopachrome tautomerase: Implication for skin photoprotection against UVA radiation. Free Radic. Biol. Med. 2010, 48, 1144–1151. [Google Scholar] [CrossRef] [PubMed]
- Ito, S.; Suzuki, N.; Takebayashi, S.; Commo, S.; Wakamatsu, K. Neutral pH and copper ions promote eumelanogenesis after the dopachrome stage. Pigment Cell Melanoma Res. 2013, 26, 817–825. [Google Scholar] [CrossRef] [PubMed]
- Schallreuter, K.U.; Kothari, S.; Chavan, B.; Spencer, J.D. Regulation of melanogenesis—Controversies and new concepts. Exp. Dermatol. 2008, 17, 395–404. [Google Scholar] [CrossRef] [PubMed]
- Korumilli, T.; Susmita, M. Production of Melanin by Soil Microbial Isolate on Fruit Waste Extract: Two Step Optimization of Key Parameters. Biotechnol. Rep. 2014, 4, 139–146. [Google Scholar]
- McCormick, J.J.; Blomquist, J.C.; Rusch, H.P. Isolation and Characterization of a Galactosamine Wall from Spores and Spherules of Physarum polycephalum. J. Bacteriol. 1970, 104, 1119–1125. [Google Scholar] [CrossRef]
- Krzywda, A.; Petelenz, E.; Michalczyk-Wetula, D.; Plonka, P. Sclerotia of the acellular (true) slime mould Fuligo septica as a model to study melanization and anabiosis. Cell. Mol. Biol. Lett. 2008, 13, 130–143. [Google Scholar] [CrossRef]
- Rakoczy, L. Plasmodial pigmentation of the acellular slime mould Physarum polycephalum in relation to the irradiation period. Pol. J. Environ. Stud. 1998, 7, 337–342. [Google Scholar]
- Liu, Y.; Simon, J. Isolation and Biophysical Studies of Natural Eumelanins: Applications of Imaging Technologies and Ultrafast Spectroscopy. Pigment Cell Res. 2004, 16, 606–618. [Google Scholar] [CrossRef] [PubMed]
- Liu, Y.; Simon, J. Metal-ion interactions and the structural organization of Sepia eumelanin. Pigment Cell Res. 2005, 18, 42–48. [Google Scholar] [CrossRef] [PubMed]
- Watt, A.; Bothma, J.; Meredith, P. The supramolecular structure of melanin. Soft Matter 2009, 5, 3754–3760. [Google Scholar] [CrossRef]
- Kim, D.; Ju, K.-y.; Lee, J.-K. The Synthetic Melanin Nanoparticles Having An Excellent Binding Capacity of Heavy Metal Ions. Bull. Korean Chem. Soc. 2012, 33, 3788–3792. [Google Scholar] [CrossRef]
- Büngeler, A.; Hämisch, B.; Huber, K.; Bremser, W.; Strube, O. Insight into the Final Step of the Supramolecular Buildup of Eumelanin. Langmuir 2017, 33, 6895–6901. [Google Scholar] [CrossRef]
- Land, E.; Ramsden, C.; Riley, P. Quinone Chemistry and Melanogenesis. Methods Enzymol. 2004, 378, 88–109. [Google Scholar]
- McGraw, K.; Wakamatsu, K.; Ito, S.; Nolan, P.; Jouventin, P.; Dobson, F.; Austic, R.; Safran, R.; Siefferman, L.; Hill, G.; et al. You Can’t Judge a Pigment by its Color: Carotenoid and Melanin Content of Yellow and Brown Feathers in Swallows, Bluebirds, Penguins, and Domestic Chickens. Condor 2004, 106, 390–395. [Google Scholar] [CrossRef]
- McGraw, K.; Safran, R.; Wakamatsu, K. How feather colour reflects its melanin content. Funct. Ecol. 2005, 19, 816. [Google Scholar] [CrossRef]
- Ito, S.; Wakamatsu, K. Chemistry of Mixed Melanogenesis—Pivotal Roles of Dopaquinone. Photochem. Photobiol. 2008, 84, 582–592. [Google Scholar] [CrossRef]
- Baker, B.I. The Role of Melanin-Concentrating Hormone in Color Change. Ann. N. Y. Acad. Sci. 1993, 680, 279–289. [Google Scholar] [CrossRef]
- Sugumaran, M. Unified mechanism for sclerotization of insect cuticle. Adv. Insect Physiol. 1998, 27, 229–334. [Google Scholar]
- Ito, S.; Fujita, K.; Yoshioka, M.; Sienko, D.; Nagatsu, T. Identification of 5-S- and 2-S-cysteinyldopamine and 5-S-glutathionyldopamine formed from dopamine by high-performance liquid chromatography with electrochemical detection. J. Chromatogr. B Biomed. Sci. Appl. 1986, 375, 134–140. [Google Scholar] [CrossRef]
- Napolitano, A.; Panzella, L.; Leone, L.; d’Ischia, M. Red Hair Benzothiazines and Benzothiazoles: Mutation-Inspired Chemistry in the Quest for Functionality. Acc. Chem. Res. 2012, 46, 519–528. [Google Scholar] [CrossRef] [PubMed]
- Greco, G.; Panzella, L.; Verotta, L.; d’Ischia, M.; Napolitano, A. Uncovering the Structure of Human Red Hair Pheomelanin: Benzothiazolylthiazinodihydroisoquinolines As Key Building Blocks. J. Nat. Prod. 2011, 74, 675–682. [Google Scholar] [CrossRef] [PubMed]
- Wolnicka-Glubisz, A.; Pecio, A.; Podkowa, D.; Kolodziejczyk, L.M.; Plonka, P.M. Pheomelanin in the skin of Hymenochirus boettgeri (Amphibia: Anura: Pipidae). Exp. Dermatol. 2012, 21, 537–540. [Google Scholar] [CrossRef] [PubMed]
- Ito, S.; Wakamatsu, K. Quantitative Analysis of Eumelanin and Pheomelanin in Humans, Mice, and Other Animals: A Comparative Review. Pigment Cell Res. 2003, 16, 523–531. [Google Scholar] [CrossRef]
- Galván, I.; Møller, A.P. Pheomelanin-Based Plumage Coloration Predicts Survival Rates in Birds. Physiol. Biochem. Zool. PBZ 2013, 86, 184–192. [Google Scholar] [CrossRef]
- Galván, I.; Jorge, A.; Nielsen, J.T.; Møller, A.P. Pheomelanin synthesis varies with protein food abundance in developing goshawks. J. Comp. Physiol. B 2019, 189, 441–450. [Google Scholar] [CrossRef]
- Galván, I.; Jorge, A.; Edelaar, P.; Wakamatsu, K. Insects synthesize pheomelanin. Pigment Cell Melanoma Res. 2015, 28, 599–602. [Google Scholar] [CrossRef]
- Dang, M.; Nowell, C.; Nguyen, T.; Bach, L.; Sonne, C.; Nørregaard, R.; Stride, M.; Nowak, B. Characterisation and 3D structure of melanomacrophage centers in shorthorn sculpins (Myoxocephalus scorpius). Tissue Cell 2019, 57, 34–41. [Google Scholar] [CrossRef]
- Ivins, B.E.; Holmes, R.K. Factors affecting phaeomelanin production by a melanin-producing (mel) mutant of Vibrio cholerae. Infect. Immun. 1981, 34, 895–899. [Google Scholar] [CrossRef] [PubMed]
- Xie, W.; Pakdel, E.; Liang, Y.; Kim, Y.J.; Liu, D.; Sun, L.; Wang, X. Natural Eumelanin and Its Derivatives as Multifunctional Materials for Bioinspired Applications: A Review. Biomacromolecules 2019, 20, 4312–4331. [Google Scholar] [CrossRef]
- Ye, M.; Chen, X.; Li, G.; Guo, G.; Yang, L. Structural Characteristics of Pheomelanin-Like Pigment from Lachnum Singerianum; Trans Tech Publications: Zurich, Switzerland, 2011; Volume 284, pp. 1742–1745. [Google Scholar]
- d’Ischia, M.; Napolitano, A.; Vincent, B.; Chen, C.-T.; Buehler, M. Polydopamine and Eumelanin: From Structure-Property Relationships to a Unified Tailoring Strategy. Acc. Chem. Res. 2014, 46, 3541–3550. [Google Scholar] [CrossRef] [PubMed]
- Tan, Y.; Deng, W.; Li, Y.; Huang, Z.; Meng, Y.; Xie, Q.; Ma, M.; Yao, S. Polymeric Bionanocomposite Cast Thin Films with In Situ Laccase-Catalyzed Polymerization of Dopamine for Biosensing and Biofuel Cell Applications. J. Phys. Chem. B 2010, 114, 5016–5024. [Google Scholar] [CrossRef] [PubMed]
- Bush, W.; Garguilo, J.; Zucca, F.; Albertini, A.; Zecca, L.; Edwards, G.; Nemanich, R.; Simon, J. The surface oxidation potential of human neuromelanin reveals a spherical architecture with a pheomelanin core and eumelanin surface. Proc. Natl. Acad. Sci. USA 2006, 103, 14785–14789. [Google Scholar] [CrossRef] [PubMed]
- El-Naggar, N. Chapter 11-Streptomyces-based cell factories for production of biomolecules and bioactive metabolites. In Microbial Cell Factories Engineering for Production of Biomolecules; Academic Press: Cambridge, MA, USA, 2021; pp. 183–234. [Google Scholar]
- Plonka, P.; Grabacka, M. Melanin synthesis in microorganisms-Biotechnological and medical aspects. Acta Biochim. Pol. 2006, 53, 429–443. [Google Scholar] [CrossRef] [PubMed]
- Vasanthakumar, A.; DeAraujo, A.; Mazurek, J.; Schilling, M.; Mitchell, R. Pyomelanin production in Penicillium chrysogenum is stimulated by L-Tyrosine. Microbiology 2015, 161, 1211–1218. [Google Scholar] [CrossRef]
- Dadachova, E.; Bryan, R.; Huang, X.; Moadel, T.; Schweitzer, A.; Aisen, P.; Nosanchuk, J.; Casadevall, A. Ionizing Radiation Changes the Electronic Properties of Melanin and Enhances the Growth of Melanized Fungi. PLoS ONE 2007, 2, e457. [Google Scholar] [CrossRef]
- Jangir, R.; Gadre, S.; Argade, N. Sulfuryl Chloride Promoted gem-Dichlorination–Dehydrochlorination in Alkyl Benzothiazinylacetates: Synthesis of the Skeleton of Trichochrome Pigments. Synthesis 2015, 47, 2631–2634. [Google Scholar]
- Ando, H.; Niki, Y.; Ito, M.; Akiyama, K.; Matsui, M.; Yarosh, D.; Ichihashi, M. Melanosomes Are Transferred from Melanocytes to Keratinocytes through the Processes of Packaging, Release, Uptake, and Dispersion. J. Investig. Dermatol. 2011, 132, 1222–1229. [Google Scholar] [CrossRef]
- Mason, H.S. The chemistry of melanin: III. mechanism of the oxidation of dihydroxyphenylalanine by tyrosinase. J. Biol. Chem. 1948, 172, 83–99. [Google Scholar] [CrossRef] [PubMed]
- Raper, H.S. The Tyrosinase-Tyrosine Reaction: Production of l-3.4-Dihydroxyphenylalanine from Tyrosine. Biochem. J. 1926, 20, 735–742. [Google Scholar] [CrossRef] [PubMed]
- Blau, N.; van Spronsen, F.J.; Levy, H.L. Phenylketonuria. Lancet 2010, 376, 1417–1427. [Google Scholar] [CrossRef]
- Lerner, A.B.; Fitzpatrick, T.B. Biochemistry of melanin formation. Physiol. Rev. 1950, 30, 91–126. [Google Scholar] [CrossRef] [PubMed]
- Solano, F.; García-Borrón, J. Enzymology of melanin formation. In The Pigmentary System: Physiology and Pathophysiology, 2nd ed.; Wiley: Hoboken, NJ, USA, 2007; Volume 1229, pp. 261–281. [Google Scholar]
- Lai; Wichers, H.; Soler-López, M.; Dijkstra, B. Phenylthiourea Binding to Human Tyrosinase-Related Protein 1. Int. J. Mol. Sci. 2020, 21, 915. [Google Scholar] [CrossRef]
- Pawelek, J.; Wong, G.; Sansone, M.; Morowitz, J. Molecular biology of pigment cells. Molecular controls in mammalian pigmentation. Yale J. Biol. Med. 1973, 46, 430–443. [Google Scholar]
- Panzella, L.; Ebato, A.; Napolitano, A.; Koike, K. The Late Stages of Melanogenesis: Exploring the Chemical Facets and the Application Opportunities. Int. J. Mol. Sci. 2018, 19, 1753. [Google Scholar] [CrossRef]
- Kwak, T.-j.; Chang, M.-Y.; Sangmin, L.; Park, S.-K.; Park, S.-N. Comparative Study of Melanin Content in Corneocyte with Skin Color. J. Soc. Cosmet. Sci. Korea 2010, 36, 193–198. [Google Scholar]
- Xiao, M.; Chen, W.; Li, W.; Zhao, J.; Hong, Y.-l.; Nishiyama, Y.; Miyoshi, T.; Shawkey, M.; Dhinojwala, A. Elucidation of the hierarchical structure of natural eumelanins. J. R. Soc. Interface 2018, 15, 20180045. [Google Scholar] [CrossRef]
- Ito, S. A Chemist’s View of Melanogenesis. Pigment Cell Res. 2003, 16, 230–236. [Google Scholar] [CrossRef]
- Pascoe, P.A.; Hadley, M.E. Endocrinology, 4th ed.; Trends in Endocrinology Metabolism; Prentice Hall: Upper Saddle River, NJ, USA, 1996; Volume 7, 518p. [Google Scholar]
- Yen, P.M. Physiological and molecular basis of thyroid hormone action. Physiol. Rev. 2001, 81, 1097–1142. [Google Scholar] [CrossRef] [PubMed]
- Pawelek, J.; Bolognia, J.; McLane, J.; Murray, M.; Osber, M.; Słominski, A. A possible role for melanin precursors in regulating both pigmentation and proliferation of melanocytes. Prog. Clin. Biol. Res. 1988, 256, 143–154. [Google Scholar] [PubMed]
- Pawelek, J.M.; Osber, M.P. Phosphorylated Derivatives of L-Dopa and Compositions and Methods for Increasing the Melanin Content in Mammalian Skin and Hair. U.S. Patent No. 5,100,654, 31 March 1990. [Google Scholar]
- Slominski, A.; Zmijewski, M.A.; Pawelek, J. L-tyrosine and L-dihydroxyphenylalanine as hormone-like regulators of melanocyte functions. Pigment Cell Melanoma Res. 2012, 25, 14–27. [Google Scholar] [CrossRef]
- McLane, J.; Osber, M.; Pawelek, J.M. Phosphorylated isomers of L-dopa stimulate MSH binding capacity and responsiveness to MSH in cultured melanoma cells. Biochem. Biophys. Res. Commun. 1987, 145, 719–725. [Google Scholar] [CrossRef] [PubMed]
- Slominski, A.T.; Jastreboff, P.J.; Pawelek, J.M. L-Tyrosine stimulates induction of tyrosinase activity by MSH and reduces cooperative interactions between MSH receptors in hamster melanoma cells. Biosci. Rep. 1989, 9, 579–586. [Google Scholar] [CrossRef] [PubMed]
- Slominski, A.; Pawelek, J. MSH binding in Bomirski amelanotic hamster melanoma cells is stimulated by L-tyrosine. Biosci. Rep. 1987, 7, 949–954. [Google Scholar] [CrossRef] [PubMed]
- Fukuzawa, T.; Bagnara, J.T. Control of Melanoblast Differentiation in Amphibia by α-Melanocyte Stimulating Hormone, a Serum Melanization Factor, and a Melanization Inhibiting Factor. Pigment Cell Res. 1989, 2, 171–181. [Google Scholar] [CrossRef]
- Chakraborty, A.K.; Funasaka, Y.; Slominski, A.; Bolognia, J.; Sodi, S.; Ichihashi, M.; Pawelek, J.M. UV light and MSH receptors. Ann. N. Y. Acad. Sci. 1999, 885, 100–116. [Google Scholar] [CrossRef]
- Skobowiat, C.; Dowdy, J.; Sayre, R.; Tuckey, R. Cutaneous hypothalamic-pituitary-adrenal axis homolog: Regulation by ultraviolet radiation. Am. J. Physiol. Endocrinol. Metab. 2011, 301, 484–493. [Google Scholar] [CrossRef]
- Pawelek, J.M.; Chakraborty, A.K.; Osber, M.P.; Orlow, S.J.; Min, K.K.; Rosenzweig, K.E.; Bolognia, J.L. Molecular Cascades in UV Induced Melanogenesis: A Central Role for Melanotropins? Pigment. Cell Res. 1992, 5, 348–356. [Google Scholar] [CrossRef]
- Slominski, A.T.; Zmijewski, M.A.; Plonka, P.M.; Szaflarski, J.P.; Paus, R. How UV Light Touches the Brain and Endocrine System Through Skin, and Why. Endocrinology 2018, 159, 1992–2007. [Google Scholar] [CrossRef] [PubMed]
- Slominski, A.; Tobin, D.J.; Shibahara, S.; Wortsman, J. Melanin Pigmentation in Mammalian Skin and Its Hormonal Regulation. Physiol. Rev. 2004, 84, 1155–1228. [Google Scholar] [CrossRef] [PubMed]
- Abdel-Malek, Z.A.; Kadekaro, A.L.; Swope, V.B. Stepping up melanocytes to the challenge of UV exposure. Pigment Cell Melanoma Res. 2010, 23, 171–186. [Google Scholar] [CrossRef]
- Palumbo, A.; d’Ischia, M.; Misuraca, G.; Prota, G. Mechanism of inhibition of melanogenesis by hydroquinone. Biochim. Et Biophys. Acta 1991, 1073, 85–90. [Google Scholar] [CrossRef] [PubMed]
- Jara, J.R.; Solano, F.; Garcia-Borron, J.C.; Aroca, P.; Lozano, J.A. Regulation of mammalian melanogenesis. II: The role of metal cations. Biochim. Et Biophys. Acta 1990, 1035, 276–285. [Google Scholar] [CrossRef] [PubMed]
- Aroca, P.; Garcia-Borron, J.C.; Solano, F.; Lozano, J.A. Regulation of mammalian melanogenesis. I: Partial purification and characterization of a dopachrome converting factor: Dopachrome tautomerase. Biochim. Et Biophys. Acta 1990, 1035, 266–275. [Google Scholar] [CrossRef]
- Slominski, A.; Wortsman, J.; Luger, T.; Paus, R.; Solomon, S. Corticotropin releasing hormone and proopiomelanocortin involvement in the cutaneous response to stress. Physiol. Rev. 2000, 80, 979–1020. [Google Scholar] [CrossRef]
- Levine, N.; Sheftel, S.N.; Eytan, T.; Dorr, R.T.; Hadley, M.E.; Weinrach, J.C.; Ertl, G.A.; Toth, K.; McGee, D.L.; Hruby, V.J. Induction of skin tanning by subcutaneous administration of a potent synthetic melanotropin. JAMA 1991, 266, 2730–2736. [Google Scholar] [CrossRef]
- Slominski, A.T.; Slominski, R.M.; Raman, C.; Chen, J.Y.; Athar, M.; Elmets, C. Neuroendocrine signaling in the skin with a special focus on the epidermal neuropeptides. Am. J. Physiol. Cell Physiol. 2022, 323, 1757–1776. [Google Scholar] [CrossRef]
- Schaffer, J.; Bolognia, J. The melanocortin-1 receptor: Red hair and beyond. Arch. Dermatol. 2001, 137, 1477–1485. [Google Scholar] [CrossRef]
- Sturm, R.A.; Teasdale, R.D.; Box, N.F. Human pigmentation genes: Identification, structure and consequences of polymorphic variation. Gene 2001, 277, 49–62. [Google Scholar] [CrossRef] [PubMed]
- Scisłowski, P.W.D.; Slominski, A.T. The role of NADP-dependent dehydrogenases in hydroxylation of tyrosine in hamster melanoma. Neoplasma 1983, 30, 239–243. [Google Scholar] [PubMed]
- Scisłowski, P.W.; Słomiński, A.; Bomirski, A.; Zydowo, M. Metabolic characterization of three hamster melanoma variants. Neoplasma 1985, 32, 593–598. [Google Scholar] [PubMed]
- Slominski, A.; Kim, T.K.; Brożyna, A.A.; Janjetovic, Z.; Brooks, D.L.P.; Schwab, L.P.; Skobowiat, C.; Jóźwicki, W.; Seagroves, T.N. The role of melanogenesis in regulation of melanoma behavior: Melanogenesis leads to stimulation of HIF-1α expression and HIF-dependent attendant pathways. Arch. Biochem. Biophys. 2014, 563, 79–93. [Google Scholar] [CrossRef]
- Zbytek, B.; Slominski, R. Inhibitors of melanogenesis increase toxicity of cyclophosphamide and lymphocytes against melanoma cells. Int. J. Cancer 2009, 124, 1470–1477. [Google Scholar]
- Brożyna, A.; VanMiddlesworth, L. Inhibition of melanogenesis as a radiation sensitizer for melanoma therapy. Int. J. Cancer 2008, 123, 1448–1456. [Google Scholar] [CrossRef]
- Nicolaus, R.A.; Piattelli, M.; Fattorusso, E. The structure of melanins and melanogenesis—IV: On some natural melanins. Tetrahedron 1964, 20, 1163–1172. [Google Scholar] [CrossRef]
- Boeckx, T.; Winters, A.; Webb, K.; Kingston-Smith, A. Detection of Potential Chloroplastic Substrates for Polyphenol Oxidase Suggests a Role in Undamaged Leaves. Front. Plant Sci. 2017, 8, 237. [Google Scholar] [CrossRef]
- Nicolas, J.; Richard-Forget, F.; Goupy, P.; Amiot, M.J.; Aubert, S. Enzymatic browning reactions in apple and apple products. Crit. Rev. Food Sci. Nutr. 1994, 34, 109–157. [Google Scholar] [CrossRef]
- Sullivan, M. Beyond brown: Polyphenol oxidases as enzymes of plant specialized metabolism. Front. Plant Sci. 2015, 5, 783. [Google Scholar] [CrossRef]
- Funa, N.; Ohnishi, Y.; Fujii, I.; Shibuya, M.; Ebizuka, Y.; Horinouchi, S. A new pathway for polyketide synthesis in microorganisms. Nature 1999, 400, 897–899. [Google Scholar] [CrossRef] [PubMed]
- Hernández-Romero, D.; Solano, F.; Sanchez-Amat, A. Polyphenol oxidase activity expression in Ralstonia solanacearum. Appl. Environ. Microbiol. 2005, 71, 6808–6815. [Google Scholar] [CrossRef] [PubMed]
- Shalaby, A.S.; Ragab, T.; Helal, M.; Esawy, M. Optimization of Bacillus licheniformis MAL tyrosinase: In vitro anticancer activity for brown and black eumelanin. Heliyon 2019, 5, e01657. [Google Scholar] [CrossRef] [PubMed]
- Eisenman, H.; Casadevall, A. Synthesis and assembly of fungal melanin. Appl. Microbiol. Biotechnol. 2011, 93, 931–940. [Google Scholar] [CrossRef] [PubMed]
- Chen, Z.; Nunes, M.; Silva, M.d.C.; Rodrigues, C. Appressorium Turgor Pressure of Colletotrichum kahawae Might Have a Role in Coffee Cuticle Penetration. Mycologia 2004, 96, 1199–1208. [Google Scholar] [CrossRef] [PubMed]
- Anuradha; Parsad, D. FK506 regulates pigmentation by maturing the melanosome and facilitating their transfer to keratinocytes. Dermatol. Ther. 2016, 29, 199–209. [Google Scholar] [CrossRef] [PubMed]
- Kim, J.; Kim, D.S.; Sohn, H.; Lee, E.J.; Oh, S. PAR-2 is involved in melanogenesis by mediating stem cell factor production in keratinocytes. Exp. Dermatol. 2016, 25, 487–489. [Google Scholar] [CrossRef]
- Wasmeier, C.; Hume, A.; Bolasco, G.; Seabra, M. Melanosomes at a glance. J. Cell Sci. 2009, 121, 3995–3999. [Google Scholar] [CrossRef]
- Wu, X.; Hammer, J. Melanosome transfer: It is best to give and receive. Curr. Opin. Cell Biol. 2014, 29, 1–7. [Google Scholar] [CrossRef]
- Wu, X.; Bowers, B.; Rao, K.; Wei, Q.; Hammer, J.A. Visualization of Melanosome Dynamics within Wild-Type and Dilute Melanocytes Suggests a Paradigm for Myosin V Function In Vivo. J. Cell Biol. 1998, 143, 1899–1918. [Google Scholar] [CrossRef]
- Slominski, A.; Paus, R.; Schadendorf, D. Melanocytes as “Sensory” and Regulatory Cells in the Epidermis. J. Theor. Biol. 1993, 164, 103–120. [Google Scholar] [CrossRef] [PubMed]
- Boissy, R. Melanosome transfer to and translocation in the keratinocyte. Exp. Dermatol. 2003, 12, 5–12. [Google Scholar] [CrossRef] [PubMed]
- Herman, K.G.; Steinberg, R.H. Melanosome metabolism in the retinal pigmented epithelium of the opossum. Cell Tissue Res. 1982, 227, 485–507. [Google Scholar] [CrossRef] [PubMed]
- Bleehen, S.S. Ultrastructural studies on tumours and cell cultures of the Harding–Passey mouse melanoma. Br. J. Derm. 1974, 90, 637–648. [Google Scholar] [CrossRef]
- Clancy, C.; Nofsinger, J.; Hanks, R.; Simon, J. A Hierarchical Self-Assembly of Eumelanin. J. Phys. Chem. B 2000, 104, 7871–7873. [Google Scholar] [CrossRef]
- Mishima, Y. Macromolecular Changes In Pigmentary Disorders. Arch. Dermatol. 1965, 91, 519–557. [Google Scholar] [CrossRef]
- Wolff, K.; Hönigsmann, H. Are melanosome complexes lysosomes? J. Investig. Dermatol. 1972, 59, 170–176. [Google Scholar] [CrossRef]
- Wolff, K. Melanocyte-keratinocyte interactions in vivo: The fate of melanosomes. Yale J. Biol. Med. 1973, 46, 384–396. [Google Scholar]
- Zelickson, A.S.; Windhorst, D.B.; White, J.G.; Good, R.A. The Chediak-Higashi syndrome: Formation of giant melanosomes and the basis of hypopigmentation. J. Investig. Dermatol. 1967, 49, 575–581. [Google Scholar] [CrossRef]
- Laties, A.M. Ocular melanin and the adrenergic innervation to the eye. Trans. Am. Ophthalmol. Soc. 1974, 72, 560–605. [Google Scholar]
- Otaki, N.; Seiji, M. Degradation of melanosomes by lysosomes. J. Investig. Dermatol. 1971, 57, 1–5. [Google Scholar] [CrossRef] [PubMed]
- Zajac, G.; Gallas, J.; Cheng, J.; Eisner, M.; Moss, S.C.; Alvarado-Swaisgood, A.E. The fundamental unit of synthetic melanin—A verification by tunneling microscopy of X-ray-scattering results. Biochim. Et Biophys. Acta 1994, 1199, 271–278. [Google Scholar] [CrossRef] [PubMed]
- DePierre, J.W.; Ernster, L. The metabolism of polycyclic hydrocarbons and its relationship to cancer. Biochim. Et Biophys. Acta 1978, 473, 149–186. [Google Scholar] [CrossRef] [PubMed]
- Kligora, C.J.; Fair, K.P.; Clem, M.S.; Patterson, J.W. A comparison of melanin bleaching and azure blue counterstaining in the immunohistochemical diagnosis of malignant melanoma. Mod. Pathol. Off. J. United States 1999, 12, 1143–1147. [Google Scholar]
- Lyon, H.O. Theory and Strategy in Histochemistry; Springer: Berlin/Heidelberg, Germany, 1991. [Google Scholar]
- Elleder, M.; Borovanský, J. Autofluorescence of Melanins Induced by Ultraviolet Radiation and Near Ultraviolet Light. A Histochemical and Biochemical Study. Histochem. J. 2001, 33, 273–281. [Google Scholar] [CrossRef]
- Gallas, J.; Eisner, M. Fluorescence of melanin-dependence upon excitation wavelength and concentration. Photochem. Photobiol. 2008, 45, 595–600. [Google Scholar] [CrossRef]
- Korzhova, L.P.; Frolova, E.V.; Romakov, I.A. A spectrofluorometric method of recording oxidation products of eumelanin destruction. Vopr. Meditsinsko Khimii 1989, 35, 139–143. [Google Scholar]
- Rosenthal, M.H.; Kreider, J.W.; Shiman, R. Quantitative assay of melanin in melanoma cells in culture and in tumors. Anal. Biochem. 1973, 56, 91–99. [Google Scholar] [CrossRef]
- Ito, S.; Jimbow, K. Quantitative analysis of eumelanin and pheomelanin in hair and melanomas. J. Investig. Dermatol. 1983, 80, 268–272. [Google Scholar] [CrossRef]
- Pezzella, A.; d’Ischia, M.; Napolitano, A.; Palumbo, A.; Prota, G. An integrated approach to the structure of Sepia melanin. Evidence for a high proportion of degraded 5,6-dihydroxyindole-2-carboxylic acid units in the pigment backbone. Tetrahedron 1997, 53, 8281–8286. [Google Scholar] [CrossRef]
- Ito, S.; Wakamatsu, K. Melanin Chemistry and Melanin Precursors in Melanoma. J. Investig. Dermatol. 1989, 92, 261S–265S. [Google Scholar] [CrossRef] [PubMed]
- Liberti, D.; Alfieri, M.; Monti, D.; Panzella, L.; Napolitano, A. A Melanin-Related Phenolic Polymer with Potent Photoprotective and Antioxidant Activities for Dermo-Cosmetic Applications. Antioxidants 2020, 9, 270. [Google Scholar] [CrossRef] [PubMed]
- Panzella, L.; Gentile, G.; D’Errico, G.; Vecchia, N.; Errico, M.; Napolitano, A.; Carfagna, C.; d’Ischia, M. Atypical Structural and π-Electron Features of a Melanin Polymer That Lead to Superior Free-Radical-Scavenging Properties. Angew. Chem. 2013, 52, 12684–12687. [Google Scholar] [CrossRef] [PubMed]
- Della Vecchia, N.F.; Avolio, R.; Alfe, M.; Errico, M.; Napolitano, A.; d’Ischia, M. Building-Block Diversity in Polydopamine Underpins a Multifunctional Eumelanin-Type Platform Tunable Through a Quinone Control Point. Adv. Funct. Mater. 2013, 23, 1331–1340. [Google Scholar] [CrossRef]
- Liebscher, J.; Mrówczyński, R.; Scheidt, H.; Filip, C.; Hadade, N.; Turcu, R.; Bende, A.; Beck, S. Structure of Polydopamine: A Never-Ending Story? Langmuir ACS J. Surf. Colloids 2013, 29, 10539–10548. [Google Scholar] [CrossRef]
- Cheng, J.I.N.; Moss, S.C.; Eisner, M.; Zschack, P. X-ray Characterization of Melanins—I. Pigment Cell Res. 1994, 7, 255–262. [Google Scholar] [CrossRef]
- Yu, X.; Fan, H.; Liu, Y.; Shi, Z.; Jin, Z. Characterization of Carbonized Polydopamine Nanoparticles Suggests Ordered Supramolecular Structure of Polydopamine. Langmuir ACS J. Surf. Colloids 2014, 30, 5497–5505. [Google Scholar] [CrossRef]
- Suwannarach, N.; Kumla, J.; Watanabe, B.; Matsui, K.; Lumyong, S. Characterization of melanin and optimal conditions for pigment production by an endophytic fungus, Spissiomyces endophytica SDBR-CMU319. PLoS ONE 2019, 14, e0222187. [Google Scholar] [CrossRef]
- Abbas, M.; D’Amico, F.; Morresi, L.; Pinto, N.; Ficcadenti, M.; Natali, R.; Ottaviano, L.; Passacantando, M.; Cuccioloni, M.; Angeletti, M.; et al. Structural, electrical, electronic and optical properties of melanin films. Eur. Phys. J. E 2009, 28, 285–291. [Google Scholar] [CrossRef]
- Aghajanyan, A.; Hambardzumyan, A.; Hovsepyan, A.; Asaturian, R.; Vardanyan, A.; Saghiyan, A. Isolation, purification and physicochemical characterization of water-soluble Bacillus thuringiensis melanin. Pigment Cell Res. 2005, 18, 130–135. [Google Scholar] [CrossRef]
- Hu, Y.; Liu, L.; Wang, Z.; Jiang, C.; Zhu, Z.; Li, H.; Zeng, Q.; Xue, Y.; Wu, Y.; Wang, Y.; et al. Network pharmacology, molecular docking and in vivo and in vitro experiments to explore the molecular mechanism of licorice green tea beverage to scavenge oxygen free radicals. J. Food Biochem. 2022, 46, e14315. [Google Scholar] [CrossRef] [PubMed]
- Reszka, K.J.; Matuszak, Z.; Chignell, C.F. Lactoperoxidase-catalyzed oxidation of melanin by reactive nitrogen species derived from nitrite (NO2−): An EPR study. Free Radic. Biol. Med. 1998, 25, 208–216. [Google Scholar] [CrossRef]
- Matuszak, Z.; Chignell, C.F.; Reszka, K.J. The acid-catalyzed interaction of melanin with nitrite ions. An EPR investigation. Nukleonika 2015, 60, 475–481. [Google Scholar] [CrossRef]
- Zou, Y.; Zhao, Y.; Hu, W. Chemical composition and radical scavenging activity of melanin from Auricularia auricula fruiting bodies. Food Sci. Technol. 2015, 35, 253–258. [Google Scholar] [CrossRef]
- Li, C.; Ji, C.; Tang, B. Purification, characterization and biological activity of melanin from Streptomyces sp. FEMS Microbiol. Lett. 2018, 365, fny077. [Google Scholar] [CrossRef] [PubMed]
- Gonçalves, R.; Pombeiro-Sponchiado, S. Antioxidant Activity of the Melanin Pigment Extracted from Aspergillus nidulans. Biol. Pharm. Bull. 2005, 28, 1129–1131. [Google Scholar] [CrossRef] [PubMed]
- Ma, Y.-P.; Bao, Y.; Kong, X.-h.; Tian, J.; Han, B.; Zhang, J.; Chen, X.; Zhang, P.; Wang, H.; Dai, X.; et al. Optimization of Melanin Extraction from the Wood Ear Medicinal Mushroom, Auricularia auricula-judae (Agaricomycetes), by Response Surface Methodology and Its Antioxidant Activities In Vitro. Int. J. Med. Mushrooms 2018, 20, 1087–1095. [Google Scholar] [CrossRef]
- Rahmani Eliato, T.; Smith, J.; Tian, Z.; Kim, E.-S.; Hwang, W.; Andam, C.; Kim, Y.J. Melanin pigments extracted from horsehair as antibacterial agents. J. Mater. Chem. B 2020, 9, 1536–1545. [Google Scholar] [CrossRef]
- Xu, C.; Li, J.; Yang, L.; Shi, F.; Yang, L.; Ye, M. Antibacterial activity and a membrane damage mechanism of Lachnum YM30 melanin against Vibrio parahaemolyticus and Staphylococcus aureus. Food Control 2016, 73, 1445–1451. [Google Scholar] [CrossRef]
- Liu, Y.M.; Ma, W.; Wei, Y.; Xu, Y.H. Photothermal Effect-based Cytotoxic Ability of Melanin from Mytilus edulis Shells to Heal Wounds Infected with Drug-resistant Bacteria in vivo. Biomed. Environ. Sci. BES 2020, 33, 471–483. [Google Scholar]
- Balk, S. Technical Report-Ultraviolet Radiation: A Hazard to Children and Adolescents. Pediatrics 2011, 127, e791–e817. [Google Scholar] [CrossRef] [PubMed]
- Yamaguchi, N.; Kinjo, Y.; Akiba, S.; Watanabe, S. Ultraviolet Radiation and Health: From Hazard Identification to Effective Prevention. J. Epidemiol. 2000, 9, S1–S4. [Google Scholar] [CrossRef] [PubMed]
- Fajuyigbe, D.; Young, A. The Impact of Skin Colour on Human Photobiological Responses. Pigment. Cell Melanoma Res. 2016, 29, 607–618. [Google Scholar] [CrossRef] [PubMed]
- Roberts, J.E. Ultraviolet radiation as a risk factor for cataract and macular degeneration. Eye Contact Lens 2011, 37, 246–249. [Google Scholar] [CrossRef] [PubMed]
- Vijayan, V.; Jasmin, C.; Anas, A.; Parakkaparambil Kuttan, S.; Vinothkumar, S.; Perunninakulath Subrayan, P.; Nair, S. Sponge-Associated Bacteria Produce Non-cytotoxic Melanin Which Protects Animal Cells from Photo-Toxicity. Appl. Biochem. Biotechnol. 2017, 183, 396–411. [Google Scholar] [CrossRef]
- Kunwar, A.; Adhikary, B.; Kumar, J.; Barik, A.; Chattopadhyay, S.; Raghukumar, S.; Priyadarsini, I. Melanin, a promising radioprotector: Mechanisms of actions in a mice model. Toxicol. Appl. Pharmacol. 2012, 264, 202–211. [Google Scholar] [CrossRef]
- Costa, T.; Younger, R.; Poe, C.; Farmer, P.; Szpoganicz, B. Studies on Synthetic and Natural Melanin and Its Affinity for Fe(III) Ion. Bioinorg. Chem. Appl. 2012, 2012, 712840. [Google Scholar] [CrossRef]
- Manirethan, V.; Raval, K.; Rajan, R.; Thaira, H.; Balakrishnan, R.M. Kinetic and thermodynamic studies on the adsorption of heavy metals from aqueous solution by melanin nanopigment obtained from marine source: Pseudomonas stutzeri. J. Environ. Manag. 2018, 214, 315–324. [Google Scholar] [CrossRef]
- Szpoganicz, B.; Gidanian, S.; Kong, P.; Farmer, P. Metal binding by melanins: Studies of colloidal dihydroxyindole-melanin, and its complexation by Cu(II) and Zn(II) ions. J. Inorg. Biochem. 2002, 89, 45–53. [Google Scholar] [CrossRef]
- Vinay, K.; Yadav, S.; Handa, S. Zinc Deficiency and Canities: An Unusual Manifestation. JAMA Dermatol. 2014, 150, 1116–1117. [Google Scholar] [CrossRef]
- Hong, L.; Liu, Y.; Simon, J. Binding of Metal Ions to Melanin and Their Effects on the Aerobic Reactivity. Photochem. Photobiol. 2007, 80, 477–481. [Google Scholar] [CrossRef]
- Yu, X.; Gu, Z.; Shao, R.; Chen, H.; Wu, X.; Xu, W. Study on Adsorbing Chromium(VI) Ions in Wastewater by Aureobacidium pullulans Secretion of Melanin. Adv. Mater. Res. 2010, 156–157, 1378–1384. [Google Scholar] [CrossRef]
- Al-Obeed, O.; El-Obeid, A.S.; Matou-Nasri, S.; Vaali-Mohammed, M.-A.; AlHaidan, Y.; Elwatidy, M.; Al Dosary, H.; Alehaideb, Z.; Alkhayal, K.; Haseeb, A.; et al. Herbal melanin inhibits colorectal cancer cell proliferation by altering redox balance, inducing apoptosis, and modulating MAPK signaling. Cancer Cell Int. 2020, 20, 126. [Google Scholar] [CrossRef] [PubMed]
- Wolnicka-Glubisz, A.; Strickland, F.M.; Wielgus, A.; Anver, M.; Merlino, G.; De Fabo, E.C.; Noonan, F.P. A melanin-independent interaction between Mc1r and Met signaling pathways is required for HGF-dependent melanoma. Int. J. Cancer 2015, 136, 752–760. [Google Scholar] [CrossRef]
- Brożyna, A.A.; Jóźwicki, W.; Roszkowski, K.; Filipiak, J.; Slominski, A.T. Melanin content in melanoma metastases affects the outcome of radiotherapy. Oncotarget 2016, 7, 17844–17853. [Google Scholar] [CrossRef]
- Li, Y.; Liu, X.; Pan, W.; Li, N.; Tang, B. Photothermal therapy-induced immunogenic cell death based on natural melanin nanoparticles against breast cancer. Chem. Commun. 2020, 56, 1389–1392. [Google Scholar] [CrossRef]
- Li, K.; Wang, J.; Zhang, Y. Heavy metal pollution risk of cultivated land from industrial production in China: Spatial pattern and its enlightenment. Sci. Total Environ. 2022, 828, 154382. [Google Scholar] [CrossRef]
- Ma, L.Y.; Li, Q.-y.; Yu, X.; Jiang, M. Recent developments in the removal of metal-based engineered nanoparticles from the aquatic environments by adsorption. Chemosphere 2021, 291, 133089. [Google Scholar] [CrossRef]
- Yao, Z.; Jianhua, Q.; Hu, Y.; Wang, Y. Insolubilization of Chestnut Shell Pigment for Cu(II) Adsorption from Water. Molecules 2016, 21, 405. [Google Scholar] [CrossRef]
- Lindroos, M.; Hörnström, D.; Larsson, G.; Gustavsson, M.; Van Maris, A. Continuous removal of the model pharmaceutical chloroquine from water using melanin-covered Escherichia coli in a membrane bioreactor. J. Hazard. Mater. 2018, 365, 74–80. [Google Scholar] [CrossRef]
- Sajjan, S.; Santoshkumar, M.; Sanganal, S.; Karegoudar, T.B. Binding affinity of amlodipine, atorvastatin and telmisartan drugs to purified bacterial melanin pigment: A kinetic study. J. Pharm. Investig. 2013, 43, 267–278. [Google Scholar] [CrossRef]
- Sansinenea, E.; Ortiz, A. Melanin: A Solution for Photoprotection of Bacillus thuringiensis Based Biopesticides. Biotechnol. Lett. 2015, 37, 483–490. [Google Scholar] [CrossRef] [PubMed]
- Łopusiewicz, Ł.; Drozłowska, E.; Trocer, P.; Kostek, M.; Śliwiński, M.; Henriques, M.; Bartkowiak, A.; Sobolewski, P. Whey Protein Concentrate/Isolate Biofunctional Films Modified with Melanin from Watermelon (Citrullus lanatus) Seeds. Materials 2020, 13, 3876. [Google Scholar] [CrossRef] [PubMed]
- Wang, Y.; Li, T.; Ma, P.; Bai, H.; Chen, M.; Xie, Y.; Dong, W. Simultaneous Enhancements of UV-Shielding Properties and Photostability of Poly(vinyl alcohol) via Incorporation of Sepia Eumelanin. ACS Sustain. Chem. Eng. 2016, 4, 2252–2258. [Google Scholar] [CrossRef]
- Roy, S.; Shankar, S.; Rhim, J.-W. Melanin-mediated synthesis of silver nanoparticle and its use for the preparation of carrageenan-based antibacterial films. Food Hydrocoll. 2019, 88, 237–246. [Google Scholar] [CrossRef]
- Shankar, S.; Bang, Y.-J.; Rhim, J.-W. Antibacterial LDPE/GSE/Mel/ZnONP composite film-coated wrapping paper for convenience food packaging application. Food Packag. Shelf Life 2019, 22, 100421. [Google Scholar] [CrossRef]
- Yacout, S.M.; Elsawa, S.F.; Gaillard, E.R. Calf melanin immunomodulates RPE cell attachment to extracellular matrix protein. Graefes Arch. Clin. Exp. Ophthalmol. 2018, 256, 1883–1893. [Google Scholar] [CrossRef]
- Wong, S.S.W.; Rani, M.; Dodagatta-Marri, E.; Granet, O.; Kishore, U.; Bayry, J.; Latgé, J.-P.; Sahu, A.; Madan, T.; Vishukumar, A. Fungal melanin stimulates surfactant protein D-mediated opsonization of and host immune response to Aspergillus fumigatus spores. J. Biol. Chem. 2018, 293, 4901–4912. [Google Scholar] [CrossRef]
- Zhang, L.; Sheng, D.; Wang, D.; Yao, Y.; Yang, K.; Wang, Z.; Deng, L. Bioinspired Multifunctional Melanin-Based Nanoliposome for Photoacoustic/Magnetic Resonance Imaging-Guided Efficient Photothermal Ablation of Cancer. Theranostics 2018, 8, 1591–1606. [Google Scholar] [CrossRef]
- Kalka, K.; Mukhtar, H.; Turowski-Wanke, A.; Merk, H. Biomelanin Antioxidants in Cosmetics: Assessment Based on Inhibition of Lipid Peroxidation. Ski. Pharmacol. Appl. Ski. Physiol. 2000, 13, 143–149. [Google Scholar] [CrossRef]

| Pigment | Monomer Precursors |
|---|---|
| Eumelanin | tyrosine,5,6-dihydroxyindoles |
| Pheomelanin | cysteinyldopas, benzothiazines |
| Neuromelanin | dopamine, catecholamines |
| Allomelanin | 1,8-dihydroxynaphthalene, phenolic precursors |
| Pyomelanin | homogentisic acid |
| Heavy Metals | Langmuir Isotherm Model | Freundlich Isotherm Model | ||||
|---|---|---|---|---|---|---|
| qm (mg/g) | b (L/mg) | R2 | KF (mg/g) | 1/n | R2 | |
| Hg | 82.37 | 0.57 | 0.99 | 26.21 | 0.49 | 0.97 |
| Pb | 147.49 | 0.38 | 0.99 | 39.36 | 0.58 | 0.96 |
| Cr | 126.90 | 0.30 | 0.99 | 28.93 | 0.59 | 0.97 |
| Cu | 167.78 | 0.41 | 0.97 | 43.59 | 0.48 | 0.96 |
Disclaimer/Publisher’s Note: The statements, opinions and data contained in all publications are solely those of the individual author(s) and contributor(s) and not of MDPI and/or the editor(s). MDPI and/or the editor(s) disclaim responsibility for any injury to people or property resulting from any ideas, methods, instructions or products referred to in the content. |
© 2023 by the authors. Licensee MDPI, Basel, Switzerland. This article is an open access article distributed under the terms and conditions of the Creative Commons Attribution (CC BY) license (https://creativecommons.org/licenses/by/4.0/).
Share and Cite
Guo, L.; Li, W.; Gu, Z.; Wang, L.; Guo, L.; Ma, S.; Li, C.; Sun, J.; Han, B.; Chang, J. Recent Advances and Progress on Melanin: From Source to Application. Int. J. Mol. Sci. 2023, 24, 4360. https://doi.org/10.3390/ijms24054360
Guo L, Li W, Gu Z, Wang L, Guo L, Ma S, Li C, Sun J, Han B, Chang J. Recent Advances and Progress on Melanin: From Source to Application. International Journal of Molecular Sciences. 2023; 24(5):4360. https://doi.org/10.3390/ijms24054360
Chicago/Turabian StyleGuo, Lili, Wenya Li, Zhiyang Gu, Litong Wang, Lan Guo, Saibo Ma, Cuiyao Li, Jishang Sun, Baoqin Han, and Jing Chang. 2023. "Recent Advances and Progress on Melanin: From Source to Application" International Journal of Molecular Sciences 24, no. 5: 4360. https://doi.org/10.3390/ijms24054360
APA StyleGuo, L., Li, W., Gu, Z., Wang, L., Guo, L., Ma, S., Li, C., Sun, J., Han, B., & Chang, J. (2023). Recent Advances and Progress on Melanin: From Source to Application. International Journal of Molecular Sciences, 24(5), 4360. https://doi.org/10.3390/ijms24054360
